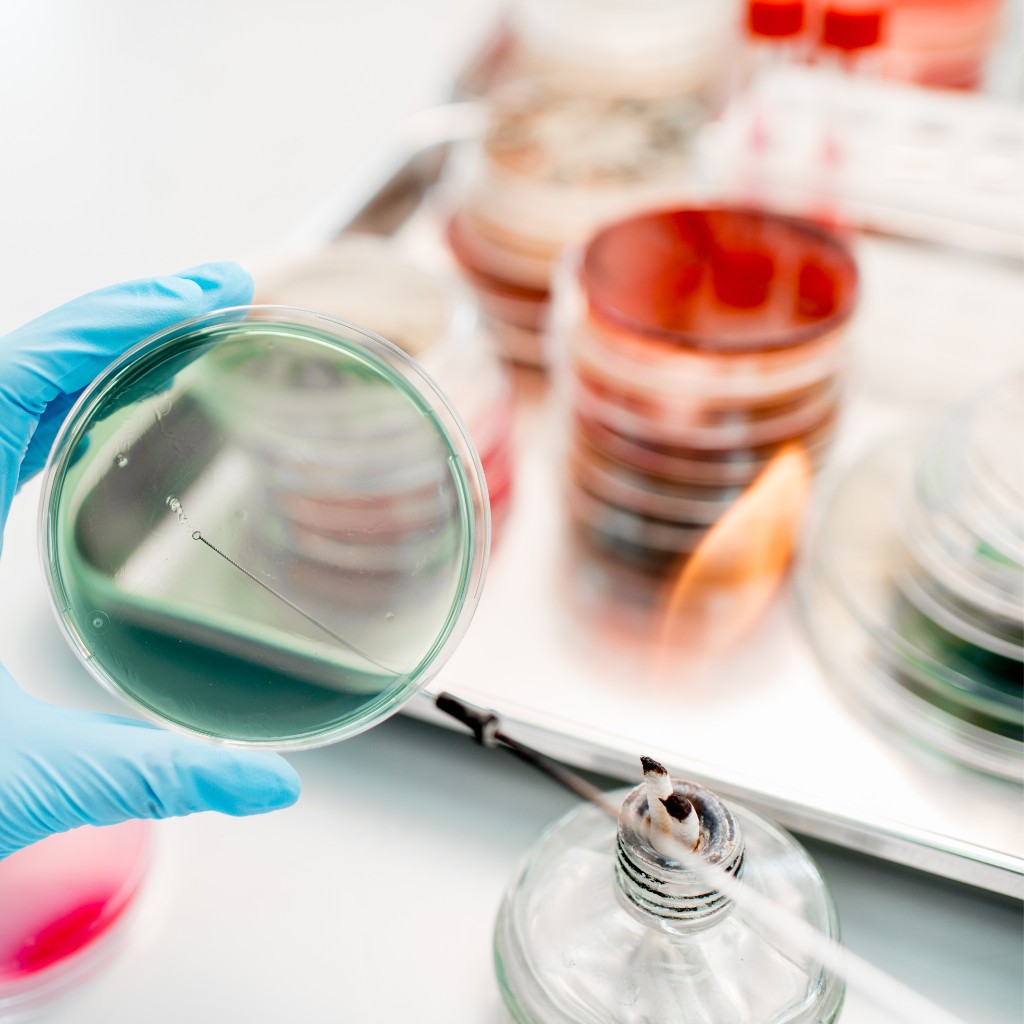
Petrischalen Beimpfung - Untersuchung des Mikrobiom im Labor

Mikrobiomanalyse
Ihr Mikrobiom ist so einzigartig wie Ihr Fingerabdruck.
Wollen Sie wissen, welche Bakterien in Ihrem Darm zuhause sind?
Inhaltsverzeichnis
Was ist OMNi-BiOTiC SCAN®?
OMNi-BiOTiC SCAN® repräsentiert die neueste Innovation in der Mikrobiomanalyse, entwickelt mit den renommierten Mikrobiom-Experten des Institut AllergoSan, wird diese Analyse in führenden Labors gemäß höchster Qualitätsstandards durchgeführt.
Die Schlüsselelemente umfassen:
Erfassung der Zusammensetzung der Darmflora: OMNi-BiOTiC SCAN® ermöglicht eine präzise Erfassung der Darmflora, um ein umfassendes Bild Ihrer mikrobiellen Gemeinschaft zu erhalten.
Leicht verständlicher Mikrobiombericht: Basierend auf den bei der Mikrobiomanalyse erhobenen Daten, wird eine detaillierte Auswertung Ihrer individuellen Darmflora erstellt.
Personalisierter Maßnahmenplan: Auf Grundlage Ihrer Ergebnisse erhalten Sie gezielte Empfehlungen, um die Gesundheit Ihrer Darmflora zu optimieren und somit Ihr allgemeines Wohlbefinden zu steigern.
Wo bekomme ich OMNi-BiOTiC SCAN®?
Sie erhalten OMNi-BiOTiC SCAN® in Ihrer Apotheke oder online:
Wie funktioniert OMNi-BiOTiC SCAN®?
Hier erhalten Sie einen umfassenderen Einblick über die grundlegenden Schritte:
OMNi-BiOTiC SCAN® Gebrauchsanweisung

Was macht OMNi-BiOTiC SCAN® so besonders?
Ein Verlust von wichtigen Bakterienarten kann metabolische, psychische und immunologische Veränderungen auslösen, die mit zahlreichen Erkrankungen (chronische Entzündungen des Darmes, Diabetes Typ 2, Leberfunktionsstörungen, Psoriasis, Krebs, etc.) sowie Allergien, Nahrungsmittelunverträglichkeiten oder auch Depressionen assoziiert sein können.
Mit über 100 publizierten Studien widmen wir uns seit Jahren dem Darm-Mikrobiom und der probiotischen Medizin, um nachzuweisen, wie mit gezielten pro- und präbiotischen Maßnahmen diese Veränderungen rückgängig gemacht und unsere Gesundheit und Lebensqualität wiederhergestellt werden können.
So einzigartig wie wir Menschen sind, so einzigartig ist auch die Zusammensetzung unseres Darm-Mikrobioms. Dazu gehört zu OMNi-BiOTiC SCAN® ein leicht verständlicher Mikrobiombericht mit individuellem Maßnahmenplan, der auf Ihre persönliche Situation und die Unterstützung Ihres speziellen Darm-Mikrobioms zugeschnitten ist.
Was ist eine Mikrobiomanalyse?
Egal ob Sie vielleicht schon einen erfolglosen Untersuchungsmarathon hinter sich haben, an Unverträglichkeiten leiden oder einfach nur vorsorglich wissen möchten, wie es um den Zustand ihrer „Gesundheitszentrale“ Darm steht, mit einer Mikrobiomanalyse erhalten Sie wertvolle Informationen über den Zustand Ihres Darm-Mikrobioms: Wie vielfältig ist die Zusammensetzung der Darmflora, herrscht ein Ungleichgewicht aufgrund krankmachender Keime oder welche Schwachstellen gibt es?
OMNi-BiOTiC SCAN® ist eine Mikrobiomanalyse, bei der die in Ihrem Darm vorkommenden Darmbakterien anhand der DNA bestimmt und untersucht werden – nach modernsten wissenschaftlichen Methoden.
Wollen Sie wissen, welches OMNi-BiOTiC® das richtige für Sie ist – machen Sie den OMNi-BiOTiC SCAN®!
Gerne interpretieren wir Ihren Mikrobiom-Status.
6 gute Gründe für eine Mikrobiomanalyse
Verdauungsstörungen zählen zu den häufigsten Beschwerden unserer Zeit. Verstopfung, Durchfälle, Blähungen, Bauchschmerzen sind nicht nur unangenehm, sondern auch Symptome für ein Ungleichgewicht des Darm-Mikrobioms.
Normalerweise verhindert die Darmschleimhaut das Eindringen von Fremdstoffen und Allergenen – ist sie geschädigt, können diese Stoffe unkontrolliert ins Gefäßsystem eindringen: Nahrungsmittelunverträglichkeiten und Allergien sind die Folge.
Die Haut spiegelt den Zustand der Darmschleimhaut wider: Wissenschaftliche Untersuchungen haben gezeigt, dass bei Menschen mit Neurodermitis, Psoriasis, Rosacea oder Akne oft ein Ungleichgewicht im Mikrobiom besteht.
Über die Darm-Hirn-Achse steuert der Verdauungstrakt nicht nur Hungergefühl und Appetit, sondern beeinflusst auch Stimmungslage, Emotionen und kognitive Prozesse. Je gesünder das Mikrobiom, desto höher ist auch der Schutz vor Stress.
Im Darm befindet sich die Immunzentrale unseres Körpers: Mikrobiom, Darmschleimhaut und das darmassoziierte Immunsystem, in dem sich etwa 70 % aller Immunzellen des Körpers befinden, bilden ein Schutzschild gegen Viren und Keime.
Zwei Bakteriengruppen, die Firmicutes und Bacteroidetes, sind normalerweise in einem ausgewogenen Verhältnis im Darm vorhanden. Übergewichtige Menschen weisen jedoch eine hohe Konzentration an Firmicutes auf – und diese sind Spezialisten darin, besonders viele Kalorien aus der Nahrung zu gewinnen.
Unsere kompetenten Beraterinnen und Berater, bestehend aus Ärzten, Apothekern, Biologen, Ernährungsexperten und Mikrobiologen, stehen Ihnen gerne für Fragen zu unserer Mikrobiomanalyse zur Verfügung.
Medizinisch-wissenschaftliche Beratung
Montag bis Donnerstag: 8:00 Uhr bis 15:00 Uhr
Freitag: 8:00 Uhr bis 13:00 Uhr
Mit unserem OMNi-BiOTiC SCAN® möchten wir einen wertvollen Beitrag zur Förderung und Erhaltung Ihrer Gesundheit leisten. Unsere Interpretation des Darmmikrobioms ersetzt selbstverständlich keine ärztliche Untersuchung oder Diagnose und keine therapeutische Behandlung. Wir empfehlen Ihnen daher, bei Beschwerden immer auch den Arzt oder Therapeuten Ihres Vertrauens, der mit dem Mikrobiom und der Interpretation von Mikrobiomanalysen vertraut ist, zu konsultieren und laufende Therapien nur nach Rücksprache mit Ihrem Arzt abzuändern oder abzubrechen.
Dysbiose behandeln
Ein Ungleichgewicht lässt sich gut behandeln: Mit der Gabe von Probiotika können gezielt Bakterienkulturen mit speziellen Fähigkeiten zugeführt werden, die im menschlichen Darm nachweisbare, positive Effekte hervorrufen. Besonders geeignet sind Multispezies-Probiotika, deren Zusammensetzung für einen speziellen Zweck kombiniert wurde und deren positive Wirkung in wissenschaftlich anerkannten Studien nachgewiesen ist.



































